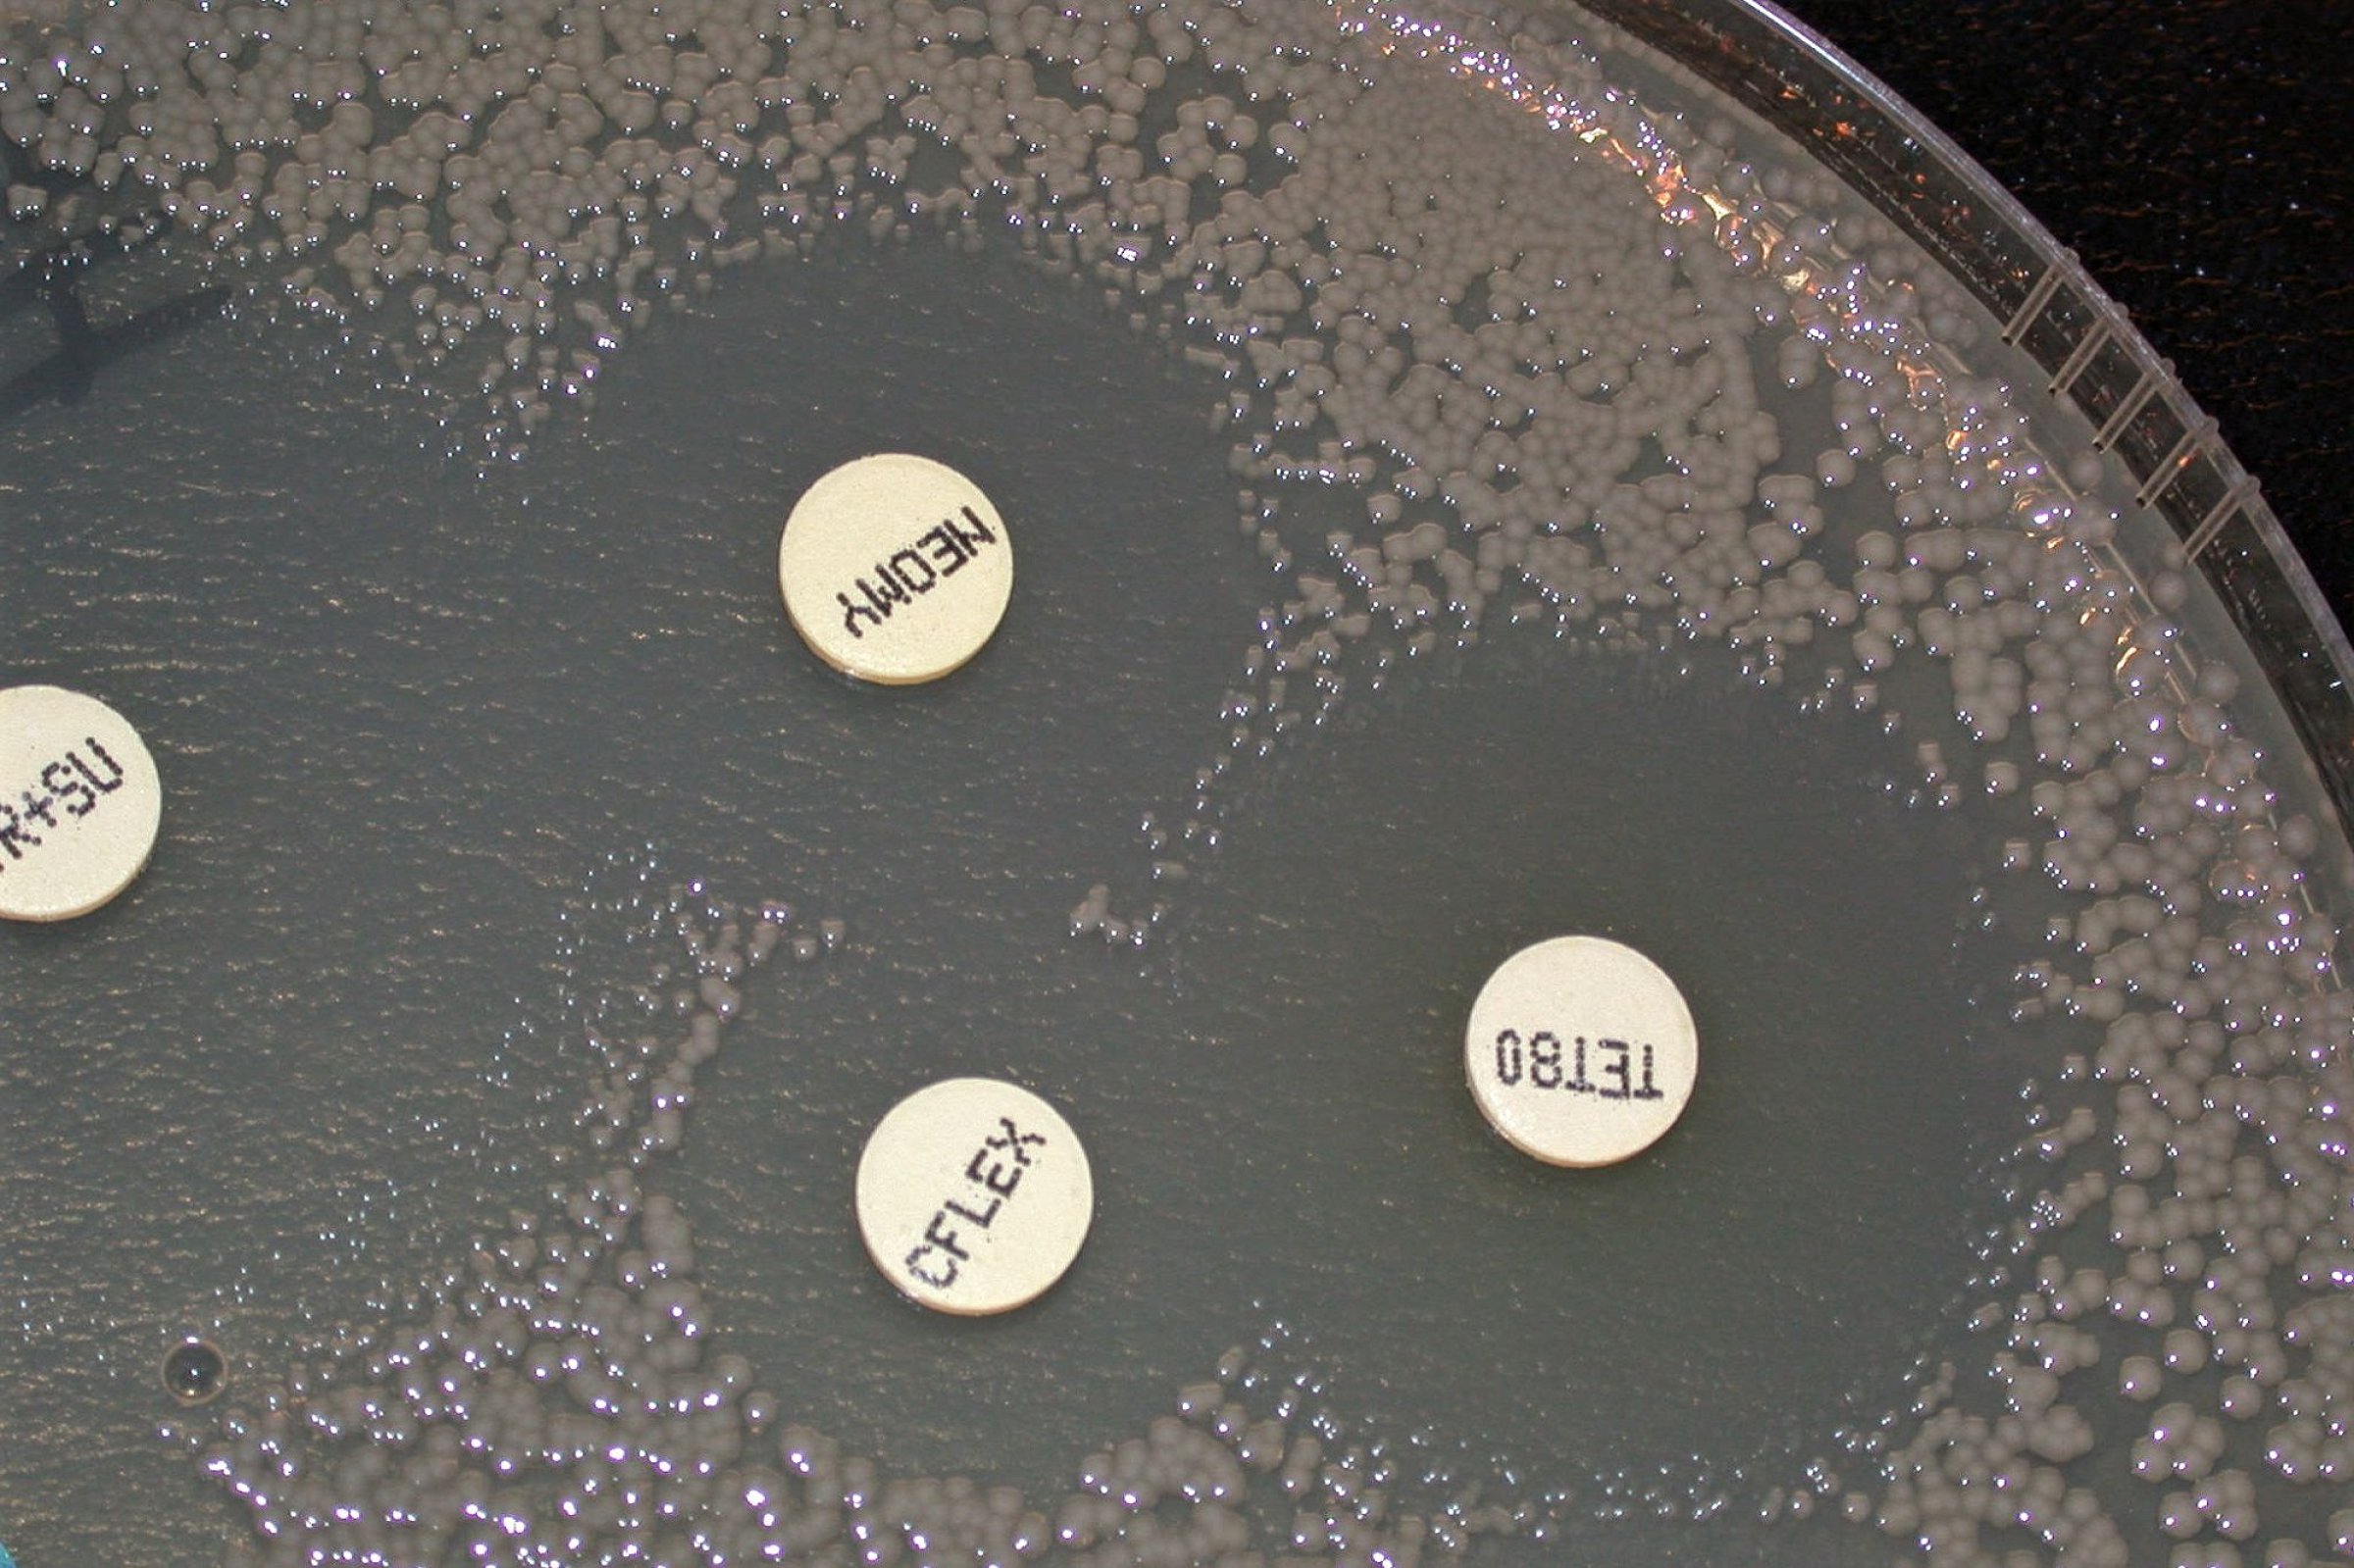

Antibiotikaforbruk og antibiotikaresistens
Antibiotika er viktig i behandling av infeksjoner som skyldes bakterier. Bruk av antibiotika kan føre til utvikling av motstandsdyktige (resistente) bakterier. Antibiotikaresistente bakterier kan spres mellom dyr, besetninger, mennesker og miljø.
Utvikling og spredning av antibiotikaresistens skjer i hovedsak som følge av at bakterier blir eksponert for antibiotika i forbindelse med behandling av infeksjoner hos dyr og mennesker. All bruk av antibiotika vil derfor i prinsippet kunne medføre utvikling av antibiotikaresistens.
Resistens mot antibiotika hos sykdomsfremkallende bakterier er et alvorlig og økende problem – både hos dyr og menneske. Både av hensyn til dyrehelsa, folkehelse og mattrygghet er det derfor viktig å bruke antibiotika riktig og bare når det er nødvendig. For å bidra til riktig bruk av antibakterielle midler er det utarbeidet terapianbefalinger for produksjonsdyr, for hest og for hund og katt. Disse er tilgjengelige fra nettsidene til Direktoratet for medisinske produkter.
Lavt forbruk av antibiotika og lav forekomst av antibiotikaresistens i Norge
Situasjonen i Norge er foreløpig gunstig. Norge er av de landene som bruker minst antibiotika til dyr og som også har lavest forekomst av antibiotikaresistente bakterier i dyrepopulasjonen. Vi ser imidlertid at det oftere påvises mer resistente bakterier nå enn for noen år siden, også i Norge.
Situasjonen i Norge påvirkes av hvor mye antibiotika som benyttes til dyr (og mennesker) i Norge, men også av faktorer som påvirker smittespredning slik som hygiene, dyretetthet, kjøp og salg av dyr etc. Resistente bakterier kan spres mellom forskjellige dyrearter, og mellom dyr og mennesker, i tillegg kan resistensegenskaper spres mellom ulike bakteriearter. Spredning kan skje indirekte via mat og fôr, ved direkte kontakt, eller via handel med dyr, dyreprodukter, mat og fôr, og også gjennom menneskers (og dyrs) reiseaktivitet.
Den globale situasjonen påvirker slik også situasjonen i Norge. Tiltak, både nasjonalt og internasjonalt, for å forebygge utvikling og spredning av antibiotikaresistens er derfor viktig for å bevare den gunstige situasjonen.
Overvåking av antibiotikaforbruk hos dyr
Forbruket av antibiotika til dyr, inkludert oppdrettsfisk, publiseres i de årlige NORM-VET rapportene. Slike data er viktige for å kunne måle effekten av tiltak for å redusere forbruket men også for å kunne følge med på om bruken av antibiotika er i tråd med gjeldende policy. Forbruksdata er også viktige for å forstå både utviklingen av og forekomsten av antibiotikaresistens.
Overvåking av antibiotikaresistens hos dyr og i mat
I regi av Norsk Overvåkingsprogram for antibiotikaResistens i Mikrober fra fôr, dyr og næringsmidler (NORM-VET) overvåkes resistensutvikling over tid, og dataene danner grunnlag for å følge trender.
→ Her kan du lese mer om overvåkingsprogrammet og laste ned årsrapportene i NORM-VET
Meldepliktige antibiotikaresistente bakterier
Forskrift om varsel og melding om sykdom hos dyr ble i 2019 endret til å inkludere meldeplikt for visse antibiotikaresistente bakterier. I praksis betyr dette at veterinærer og norske laboratorier ved påvisning av disse skal melde fra til Mattilsynet via skjemaet Meld fra om resistente bakterier (skjemaet er også tilgjengelig på nynorsk). Når prøver sendes til analyse for undersøkelse i laboratorium utenfor Norge, skal melding til Mattilsynet sendes av veterinær som er ansvarlig for prøvetakingen.
I løpet av 2021 vil vi får nytt dyrehelseregelverk i Norge, som også fører til at forskrift om varsel og melding om sykdom hos dyr blir oppdatert. Det vil da kunne komme endringer også for antibiotikaresistente bakterier. Hvilke antibiotikaresistente bakterier som til enhver tid er meldepliktig kommer fram av vedleggene i Forskrift om dyrehelse (Dyrehelseforskriften).
Her finner du «Retningslinjer for håndtering av kjæledyr og hest smittet med resistente bakterier».
Antibiotikaresistens kan være forårsaket av mange forskjellige mekanismer. For å vite hvilke mekanismer som er til stede, samt å kunne sammenlikne isolater, er det ofte behov for å karakterisere bakterieisolatene ved hjelp av genetiske metoder. Dette danner grunnlag for:
- Overvåking av forekomst og for å undersøke om en eventuell endring i resistens er forårsaket av spesielle mobile genetiske elementer (f.eks. plasmider)
- Identifisering av ukjente utbrudd (f.eks. MRSA/MRSP i et geografisk område eller knyttet til en klinikk)
Følgende isolater er ønsket innsendt til NRL-AMR ved Veterinærinstituttet slik at den nasjonale situasjonen kan overvåkes:
- Kolistinresistente Enterobacteriaceae
- ESBL/AmpC produserende Enterobacteriaceae (Enterobacteriaceae resistente mot 3. og/eller 4. generasjons cefalosporiner)
- Karbapenemaseproduserende/ karbapenemresistente Enterobacteriaceae, samt karbapenemresistente Pseudomonas og Acinetobacter
- Linezolidresistente Enterococcus faecium og E. faecalis
- MRSA (Meticillinresistente Staphylococcus aureus)
- MRSP (Meticillinresistente Staphylococcus pseudintermedius)
Ta alltid kontakt med NRL-AMR for nærmere avtale om innsendelse av isolater.
NRL-AMR kan nås på e-post: NRL-AMR@vetinst.no
Antibiotikaresistensforskning ved Veterinærinstituttet
Antimikrobiell resistens (AMR) er et av Veterinærinstituttets satsingsområder og et sentralt tema i instituttets visjon for Én helse. Utvikling og spredning av antibiotikaresistens er regnet som en av de største helseutfordringene verden står overfor. Veterinærinstituttet er sterkt involvert i forskningsprosjekter som studerer utvikling, forekomst og spredning av antibiotikaresistens, samt tiltak for å forebygge og redusere denne utviklingen.
→ Les mer om vår forskning på antibiotikaresistens her.
Lenker til noen andre overvåkningsrapporter
- Denmark. DANMAP. Use of antimicrobial agents and occurrence of antimicrobial resistance in bacteria from food animals, food and humans in Denmark. (www.danmap.org).
- EU/EØS rapporter resistens (European Food Safety Authority)
- EU/EØS rapporter forbruk (European Medicines Agency)
Rapporter
- Antimikrobiell resistens i terrestrisk miljø
- Antimikrobiell resistens hos dyr og i mat - status i Norge i 2020
- Antibiotic resistance in terrestrial wild mammal species in Norway - roe deer and wild reindeer as indicators species
- Antibakterielle midler til oppdrettsfisk og rensefisk – rekvireringer, forbruk og diagnoser 2013-2017
- Veterinært legemiddelregister (VetReg) - datakvalitet for antibakterielle midler
Forskningsprosjekt
- TEiCON
- RADAR - Risiko og sykdomsregnskap for antibiotikaresistens
- QREC-Risk - Quinolone resistant Escherichia coli in Norwegian poultry and their impact on humans
- QREC-MaP - Quinolone resistance despite low antimicrobial usage – mechanisms and possible preventive measures
- PhageDrive
- Norwegian Airways
- NoResist - Combating antimicrobial resistance in the Norwegian food production chain
- NE kalkun - Nekrotiserande enteritt hos kalkun: Forebyggande tiltak, tidleg diagnostikk og ikkje-antibiotisk behandling
- NavAzole
- LIMBO
- KLEB-GAP - Klebsiella pneumoniae, en sentral aktør i den globale spredningen av antibiotikaresistens og målbakterie for nyskapende diagnostikk, overvåkning og alternativ behandling
- IRA swine embryos - Importrisikovurdering av svineembryo
- INIKA_OH_TZ
- ICONIC
- HUNT Én helse
- Fisk for Utvikling i Ghana - Akvakultur
- EUPAHW - SPAMR-VET
- EU-WISH
- EU-JAMRAI - European Union Joint Action on Antimicrobial Resistance (AMR) and Healthcare-Associated Infections (HCAI)
- AGRISPACE - Samfunn, areal og sted: Utfordringer og muligheter for produksjon og innovasjon i landbruksbaserte verdikjeder
Nyheter
- Årets NORM-VET rapport bekrefter en fortsatt lav forekomst av antibiotikaresistens hos produksjonsdyr i Norge
- Vil bedre overvåkningen av antimikrobiell resistens globalt
- Veterinærinstituttet tilstede på åpen dag hos AniCura
- Veterinærinstituttet representert på internasjonal konferanse innen antimikrobiell resistens
- Veterinærinstituttet nytt medlem i europeisk ekspertkomité for kategorisering av antibiotikaresistente bakterier hos dyr
- Veterinærinstituttet med i stort EU-prosjekt: Hvordan redusere antibiotikabruk i voksende økonomier
- Veterinærinstituttet med i nye nettverk innen antibiotikaresistens
- Veterinærinstituttet i toppen innen resistensforskning
- Veterinærinstituttet deltar i Transatlantic Task Force on Antimicrobial Resistance (TATFAR)
- Tatt med på råd for utvikling av overvåking i India
- Skal undersøke sammenhenger mellom helsen til mennesker og dyr
- Sammen for å forebygge antimikrobiell resistens
- Resultater fra NORM-VET er nå digitalt tilgjengelig
- Resistenstester alle prøver med sykdomsfremkallende bakterier
- Possibilities and challenges in the Ghana-Norway cooperation in aquaculture
- Oppdatert kunnskap og status om antibiotikaresistens- og forbruk
- Ny forskning om streptokokker kan bli et viktig verktøy for friskere dyr i moderne norsk dyrehold
- Norsk kylling har minst resistente bakterier i Europa
- Norge tjener på å hindre antibiotikaresistens blant svin
- MRSA-smitte fra menneske til dyr må forhindres
- MRSA-overvåkingen av svin viser ingen funn hittil i 2016
- Lite antibiotikaresistens i det akvatiske miljø
- Lav forekomst av antibiotikaresistente bakterier hos villrein og rådyr i Norge
- Kritisk viktig bakterie under lupen i nytt resistensprosjekt
- Kraftig nedgang i bruk av antibiotika til dyr i Europa
- Kinolonresistens varierer mellom dyrearter
- Kartlegging av antibiotikaresistente bakterier hos hest – Veterinærinstituttet og Mattilsynet ønsker hjelp!
- Ingen funn av MRSA hos svin i 202
- Hvordan takle antibiotikaresistens
- Har nådd målet om 10 prosent reduksjon av antibiotika til matproduserende dyr
- Gode resultater for MRSA-overvåkingen også i 2017
- Fortsatt nedgang i forbruket av antibiotika til matproduserende dyr i EU/EØS-området
- Fortsatt lite antibiotikaresistens i norsk dyrehold
- Flere antibiotikaresistente bakterier blir meldepliktige
- Dyreassosiert MRSA påvist i prøver fra svin
- Dyr og menneskers helse må sees sammen i kampen mot antibiotikaresistens
- Disputas -risikofaktorer for antibiotikaresistens i norsk kylling
- Det brukes fortsatt lite antibiotika til oppdrettsfisk i Norge
- Delta i internasjonal spørreundersøkelse om bruk av antibiotika til dyr
- Bioinformatisk prosedyre på plass for analyse av bakteriers arvestoff
- Antibiotikaresistens påvist i norsk kulturlandskap
- Antibiotikaresistens hos rødrev kan knyttes til menneskelig aktivitet
- Antibiotika til kjæledyr - riktig bruk, bare når det trengs